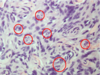

A lateral view of the cortical surface bordering the right sylvian fissure that is commonly exposed in a frontotemporal craniotomy is shown in Figure 1. The lower ends of the precentral (1) and postcentral (2) gyri are in the exposure. The supramarginal gyrus is indicated by number:
A.9
B.5
C.6
D.8
E. 7

E. 7
Bill’s bar separates the facial nerve from what other structure?
A. Greater Superficial Petrosal Nerve
B. Geniculate Ganglion
C. Superior Vestibular Nerve
D. Inferior Vestibular Nerve
C. Superior Vestibular Nerve
The figure is a cadaveric dissection of the anterior portion of the left cavernous sinus. What deficit would be seen with damage to this structure?
A. Facial numbness
B. Diplopia that corrects with head tilt
C. Periocular numbness
D. Ptosis, meiosis and anhydrosis
E. Monocular blindness
D. Ptosis, meiosis and anhydrosis
The following figure depicts an endoscopic view of the upper clival/retrosellar region in a cadaveric dissection. Which cranial nerve is indicated by numeral 1.
A. Trochlear
B. Oculomotor
C. Optic
D. Trigeminal
E. Abducens I

B. Oculomotor
Three days after clipping of a ruptured anterior communicating artery aneurysm, a patient develops contralateral paresis of the arm and face, as well as dysarthria. A cerebral angiogram reveals focal vasospasm that eventually results in infarction of the corresponding vascular territory, confirmed by CT. What vessel was most likely affected
by vasospasm in this case?
A. Recurrent artery of Haubner
B. Anterior choroidal artery
C. Distal anterior cerebral artery
D. M1 branch of the middle cerebral artery
E. Posterior communicating artery

A. Recurrent artery of Haubner
What artery (identified by the arrow in Figure 1) is encountered during a retrosigmoid approach for a vestibular schwannoma?
A. Superior cerebellar artery.
B. Anterior inferior cerebellar artery.
C. Posterior inferior cerebellar artery.
D. Vertebral artery.
E. Basilar artery.

B. Anterior inferior cerebellar artery.
What structure passes through the foramen demonstrated with the white arrow?
A. V2
B. V1
C. Vidian nerve.
D. V3.
E. Optic nerve.

A. V2
Which of the following structures of the superior orbital fissure pass around the annulus of Zinn:
A. Nasociliary nerve.
B. Inferior branch of oculomotor nerve.
C. Superior branch of oculomotor nerve.
D. Abducens nerve.
E. Trochlear nerve.
E. Trochlear nerve.
A patient presenting for resection of a small parietal meningioma has a preoperative INR
of 1.5. What is the likelihood that the transfusion of 2 units of FFP would normalize her
INR?
A. 50o/o
B. 25%
C. <5%
D. 75%
E. 95%
C. <5%
An otherwise healthy woman presents with an aneurysmal subarachnoid hemorrhage.
Admission troponin is 1.4ng/ml and transthoracic echocardiography demonstrates a left
ventricular ejection fraction of 15% with severe apical hypo-kinesis. The most likely
pathophysiological mechanism of the cardiac dysfunction is:
A. Catecholamine-induced myocardial stunning
B. Multi-vessel coronary artery spasm
C. Thrombotic coronary artery occlusion
D. Microvascular myocardial ischemia
E. Tachycardia induced cardiomyopathy
A. Catecholamine-induced myocardial stunning
Cerebral-salt wasting syndrome (CSW) can be best described as the following:
A. lso-osmolar, euvolemic hyponatremia
B. Hypo-osmolar, hypervolemic hyponatremia
C. Hypo-osmolar, hypovolemic hyponatremia
D. Hypo-osmolar, euvolemic hyponatremia
E. Hyperosmolar, hypovolemic hypernatremia
C. Hypo-osmolar, hypovolemic hyponatremia
During the creation of a burr hole for a deep brain stimulator, an awake, sedated patient develops the sudden onset of coughing, hypotension, and hypoxia. The clinical presentation suggest which of the following complications:
A. lntracranial hemorrhage
B. Aspiration pneumonia
C. Air embolism
D. Tension pneumocephalus
E. Seizure activity
C. Air embolism
What is the most concerning side effect of dexmedetomidine infusion in ICU patients?
A. Inhibition of the locus ceruleus
B. Bradycardia
C. Systolic hypertension
D. Respiratory depression
E. lntracranial hypertension
B. Bradycardia
Which of the following agents causes the largest decrease in the cerebral metabolic rate of oxygen (CMR02):
A. Sufentanil
B. Sodium thiopental
C. Ketamine
D. Diazepam
E. Propofol
B. Sodium thiopental
Which of the following opioids has the slowest peak onset?
A. Sufentanil
B. Fentanyl
C. Alfentanil
D. Remifentanil
E. Morphine
E. Morphine
Within the normal range of autoregulation, the alteration in cerebral blood flow with a 1- mmHg change in arterial carbon dioxide (PaC02) is best described by:
A. 10-11 ml/1 OOg/min
B. 4-5 ml/1 OOg/min
C. 7-8 ml/1 OOg/min
D. 1-2ml/1 OOg/min
E. 13-14ml/1 OOg/min
D. 1-2ml/1 OOg/min
A PGY-2 resident has worked 75 hours in the current week. The resident began his call
shift yesterday at 06:00. The resident had 2 days completely off work in the previous two
weeks. During the call day, the resident admits a pediatric patient with a rare brain
tumor.
The next day, the resident hands off call responsibilities to another resident. However,
he then stays to assist with a rare pediatric brain tumor resection until noon. Which ACGME duty hour rule applies?
A. Adequate rest between duty periods
B. Minimum days off
C. Maximum duty period length
D. In house call limitation
E. 80 hour workweek
C. Maximum duty period length
A Type 2 error (false negative) in interpreting clinical trials occurs when:
A. Inadequate informed consent was obtained in over half the cases.
B. A treatment is found to be ineffective but the sample size is too small.
C. A positive result relies on an incorrect statistical test.
D. The test is not randomized or controlled.
E. Gender makeup of the experimental and control populations are not equal.
B. A treatment is found to be ineffective but the sample size is too small.
A medical device company is sponsoring a presentation regarding a new implant they
have developed for treatment of spinal instability. The presentation is followed by a
modest meal at a local restaurant. At the conclusion of the meal, the company
representative passes out gifts to the attending physicians, as a “thank you” for taking
time out of their personal lives to attend a work meeting. Which of the following gifts
would be acceptable under the AMA code of ethics and Advamed guidelines?
A. Tickets to professional basketball game the following week
23`
C. $100 gift certificate to restaurant
D. Golf shirt with company logo displayed on sleeve
B. Textbook of spinal anatomy with company logo imprinted on cover
A physician chooses to utilize a questionnaire-based outcome measure in his/her
practice. The questionnaire is administered to a core group of patients and then
read ministered to the same patients within a few days. The purpose of this exercise is to
confirm that the replies to the same questions by the same patients do not change after a
few days. A statistical analysis is completed to assess the degree of similarity between
the first and second replies in this setting. This type of analysis for an outcome measure
is a reflection of its:
A. Responsiveness
B. Integrity
C. Reliability
D. Sensitivity
E. Validity
C. Reliability
According to the Accreditation Council of Continuing Medical Education {ACCME), what
type of financial relationship is both necessary and sufficient to define a conflict of
interest (COi) between a commercial interest and an individual who can affect patient
care, research activities, or data interpretation?
A. Extraordinary
B. Relevant
C. Significant
D. Monetary
B. Relevant
An appropriate way for a neurosurgeon working in a complex team environment to
mitigate stress and fatigue would be to:
A. Not acknowledge stress and fatigue, therefore reducing its effect on performance.
B. Recognize stress and fatigue, thereby increasing the use of threat and error management strategies.
C. Rely on previous experience of chronic stress and fatigue during residency training to overcome these factors.
D. Deny the existence of stress and fatigue in order to avoid distraction from the task at hand.
B. Recognize stress and fatigue, thereby increasing the use of threat and error management strategies.
Certain medical conditions are subject to mandatory physician reporting. You evaluate a recent immigrant from Mexico complaining of occasional back pain. He has not been previously evaluated by a physician in the United States. Which of the following diagnoses are required by law to report, if the patient reveals it to you as part of their medical history?
A. Inactive TB
B. Assault
C. Polio
D. Cysticercosis
E. AIDS
E. AIDS
Child abuse should be reported:
A. Only by a specially trained Child Protection expert when present in a
hospital.
B. By any physician when requested by law enforcement officials.
C. By any caregiver who suspects non-accidental traumatic injury to a child.
D. In every child under age 2 with a head injury.
C. By any caregiver who suspects non-accidental traumatic injury to a child.